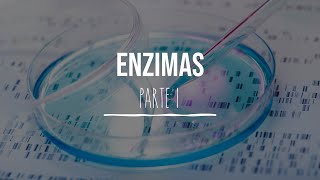
Enzimas- PARTE 1/2 - Bioquímica - Lic. en Nutrición

[Música] nosotros sabemos chicos que el metabolismo es una de las características más importantes de los seres vivos y sabéis que el metabolismo depende básicamente de quién es pues de las enzimas las enzimas chicos son moléculas orgánicas van a ser descubiertas no en 1833 por un amiguito llamado ángel me paguen [Música] descubre la primera enzima tan mal taza las enzimas las enzimas son de naturaleza proteica es decir es decir que hablando molecularmente chicos las enzimas son proteínas son proteínas y como proteínas chicos tienen origen qué cosa genético sea cada gen origina una proteína y si estamos
afirmando que las enzimas son proteínas entonces chicos cada encima mejor dicho se originó a partir de que de un gen por lo tanto chicos las proteínas y las enzimas también ahí tienen origen qué cosa genético hay enzimas que no son proteínas y esas enzimas una pregunta cómo se llama se llaman ribosomas [Música] qué son las encinas las enzimas son biocatalizadores es decir chicos que aceleran qué cosas aceleran una reacción química si nosotros chicos hipotéticamente porque esto no es cierto está bien supongamos chicos no que para que se formen esto no para que se forme qué
cosa agua vamos a balancear aquí chicos ya está cosas un chico que esta reacción ocurre espontáneamente en la naturaleza en tres horas ya esta profecía esta reacción veamos sea esta reacción chicos yo le adicionó una enzima x entonces esta reacción ya no se realiza en tres horas sino en cinco horas si nosotros chicos a esta reacción química le adicionamos una enzima y pues no se realiza ni entre 10 5 horas se realiza en una hora entonces profe disculpe y por qué razón porque hemos adicionado enzimas entonces si yo te preguntará qué es un catalizador que
es una enzima la respuesta es seria estas son aquellas sustancias que aceleran o retardar una reacción química en el ejemplo que te acabo de dar la enzima x retarda la reacción química mientras la enzima y una pregunta que hace la acelera pero te voy a decir algo cuando las enzimas están en un ser vivo dentro de un ser vivo entonces chicos ya no se llaman catalizadores sabes cómo se llaman biocatalizadores y acuérdate de esto no una enzima jamás jamás nunca retarda una reacción química siempre chicos una enzima que hace acelera la reacción química para siempre
chicos nos quedamos con lo siguiente que las enzimas son bio catalizadores que aceleran reacciones químicas chicó las enzimas muchos muy bien las enzimas disminuir la energía de activación y que la energía de activación la energía de activación chicos en la energía necesaria para que un sustrato se convierte en que en productos entonces profe que no entiendo eso mira aquí tienes aquí un sustrato y para que un sustrato se convierta en productos es necesario chicos qué cosa una energía ya esa energía le llamamos energía de que de activación te lo voy a explicar más sencillo aquí
tienes una reacción y una reacción química no catalizada es decir si yo digo no catalizar que decir aquí chicos no participan no una pregunta quienes no participan enzimas entonces para que este sustrato se convierta en productos se necesita como veis aquí se necesita bastante que energía entonces con ese energía el sustrato se convirtió en productos a esa energía utilizada se le llama energía de que de activación pero mira qué pasa cuando yo utilizo enzimas para este mismo proceso es decir para que el sustrato se convierte en productos ya no necesito tanta energía necesito menos energía
ok y ocurre lo mismo entonces gracias a esta enzima una pregunta que ocurrido pues que se disminuye que goza chicos la energía de que de activación las enzimas disminuyen el tiempo de reacción haciendo menor en tiempo de catálisis no o sea de convertir al sustrato en productos y vamos a hablar de esa misma reacción pero aquí estamos hablando de que de tiempo ok observa esa misma reacción química la que no era catalizada está bien ocurre en un lapso de tiempo x que nosotros les vamos a llamar t 1 y la segunda reacción donde intervienen enzimas
entonces una pregunta cómo le vamos a llamar de dos quizás observando que chicos cuando actúa la enzima una pregunta qué pasa con el tiempo de reacción disminuye por lo tanto chicos las enzimas las enzimas aparte de ahorrarnos energía una pregunta que nos va a ahorrar nos ahorran tiempo entonces lo que ya te había dicho que las enzimas las enzimas chicos aceleran las reacciones químicas conclusión que cuando las enzimas actúa nos hace ahorrar dos cosas chicos energía y tiempo la primera característica es que son específicas que significan que para cada reacción química actúa una enzima profe
no entiendo eso escúchame por cada reacción química al tubo una enzima y ese encima sólo puede actuar en esa reacción química y provee no entendemos mira ven por ejemplo si acá yo tengo encima el encima chicos base específica es decir que la enzima solamente podrá actuar sobre quien sobre este sustrato para que una vez unido chicos este sustrato que está aquí una pregunta se convierta en que la respuesta es se convierta en productos si aquí tienen su enzima que se llama teanina o amilasa salival y acá tienes un sustrato no un polisacárido no en este
caso chicos el almidón propio que pasa aquí pasa hijo que late al inah o amilasa salival va a degradar el almidón está bien propio primero se une comercio a los planos y lo va a ir desgranando profe que lo degrada pues los degrada chicos e indisa queridos me entiendes yo nancy propia y quede y sacaron tranquilo aquí se forma maltosa profe no entiendo eso de nuevo la tía lynn a chicos sólo actúa en la boca pregunta sobre quien sobre el almidón quiere decir que la amilasa o te harina no actúa ni sobre proteínas ni sobre
libios quiere decir que los lípidos y proteínas pasan por la boca si no eso no proteínas y lípidos profe en el estómago te estoy diciendo las proteínas son degradadas chicos porque por la pepsina sin embargo la bencina no actuaba ni sobre glúcidos ni lípidos es decir que ellos pasarán por el estómago continuando como tales no como glúcidos y limpios las enzimas chicos actúan a una determinada temperatura si aca chicos ponemos la actividad enzimática y aca la temperatura en grados centígrados en el caso chicos de las enzimas la temperatura a la cual actúa que es 37
a 39 grados centígrados que la temperatura óptima está bien si nosotros chicos subimos la temperatura por ejemplo hasta 42 grados de repente algunas de ellas ya no actúan y si bajamos la temperatura 32 grados también o algunas de ellas ya no actúan se inactiva me entiendes yo nací profe lo que pasa chicos cuando tenemos fiebre o cuando tenemos hipotermia que como ya no actúan algunas enzimas eso por ejemplo a los otros chicos mamíferos nos produciría que cause a la muerte sigamos chicos las enzimas actúan en un rango de ph determinado que significa significa chicos no
que las enzimas pueden actuar en un medio ácido o básico dependiendo de la enzima por ejemplo no para que tú tengas una idea acá yo pongo acción enzimática y acá yo pongo ph y te doy un ejemplo chiquito la tía lynn a que la habíamos visto que actúa en la boca en la boca chicos el ph cuanto es el básico 7,2 entonces chicos a ese ph óptimo actual a la tiamina al ph en el cual puede actuar una enzima el ph ideal te vuelvo a repetir se llama óptimo pero si nosotros chicos disminuimos el ph
por ejemplo cuando el bolo alimenticio llega al estómago entonces estamos hablando de un ph cercano a 1.5 entonces chico late al inah [Música] me entiendes jonas y porque ella tiene un rango de ph en el cual actor otro ejemplo no la piscina la piscina chicos a tuve un ph entre 1.5 y 4 quiere decir que la pepsina actuemos medio que hacer ok entonces el ph en el cual actor encima depende en qué órgano se muestre lo que sigamos y más no las enzimas también actúan en bajas concentraciones mire el esquema si yo tengo un sustrato
y tengo suponte una enzima ella solita podría hacer este trabajo es decir convertir el sustrato en que en productos entonces ello sea una pregunta qué pasa si aumentamos el número de enzimas y creo que la respuesta también es obvia no la reacción se realiza más rápido o sea este sustrato más rápido será convertido en que en productos otra característica chicos de las enzimas es que son solubles en agua no por él porque son globulares me entiendes jon así y no solamente son solubles en agua sino que en diluidos de salino propia y también se disuelven
en qué cosas chicos en alcohol es las proteínas chicos se desnaturaliza decir pierde en su estructura tridimensional cuando están a 100 grados centígrados es decir que son la vid es el calor las destruye profe no actuado cuando tenemos cero grados es decir cuando nosotros congelamos chicos ya las enzimas no actúa y su actividad es mayor chicos como ya lo habíamos dicho entre 37 y 45 grados correcto dependiendo obviamente chicos donde estén actuando en chicos ahora vamos a seguir hablando de las enzimas y ahora vamos a ver qué parte tiene una enzima como tú sabes una
enzima qué cosa es una enzima chicos es una proteína ese es una proteína pues obviamente está formada de que de aminoácidos como tú sabes tienen forma que un globular y esta parte chicos no lo más lo más notorio en una proteína es su cuerpo el cuerpo de esta enzima está formado de que de aminoácidos esa parte que está aquí chicos en la parte más importante de la enzima a esa se denomina sitio antiguo el sitio activo es la parte de la enzima que se va a unir con el sustrato en este sitio activo distinguimos aminoácidos
y en primer lugar tenemos esos aminoácidos que están aquí no los llamados aminoácidos de que de fijación que van a servir para que la enzima se une al sustrato hacia la parte interna observamos otros aminoácidos chicos son los aminoácidos que catalíticos y los aminoácidos catalíticos son los que van a degradar a quien al sustrato esas son las partes de una enzima vamos a hablarte de una enzima una enzima chicos es una enzima inactiva es decir que no tiene actividad catalítica o que la enzima chicos para tener actividad catalítica tiene que unirse con quien con un
factor y cuando está por encima se une con un factor resultados chicos a quien tenemos a lado la enzima que la enzima activa que la enzima que va a poder hacer catálisis estamos ahora el co factor chicos pueden ser de dos tipos tenemos en primer lugar un factor inorgánico y por acá chicos otros cofactores llamados orgánicos los con factores inorgánicos van a ser iones minerales por citarte algunos ejemplos aquí tenemos el magnesio aunque también chicos deja mencionarte al manganeso por ahí chicos el cobre y también por aquí chicos el zinc profe esos son algunos ejemplos
chicos de cofactores qué inorgánicos es decir chicos que esos cofactores se unen a la enzima para que ésta tenga actividad catalítica pero dentro de los factores orgánicos tenemos los siguientes a los co factores orgánicos déjame decirte algo que también se les llama signo pregunta como se les llama con enzimas y dentro de las co enzimas más conocidas son estas dos me lave el nac y el fat que intervienen en la respiración celular y esa que está aquí no una pregunta cómo se llama una fosfato que interviene en la fotosíntesis sin embargo chicos las co enzimas
más importantes una pregunta quiénes son las vitaminas y está bien las vitaminas no aportan energía las vitaminas no son nutrientes sin embargo chicos las vitaminas son importantes para que se formen quién es o lo enzimas y estás solo enzimas son responsables de una reacción química es decir que si tú no consumes vitaminas esas appo enzimas no se activan y por lo tanto en tu organismo dejan de haber determinadas reacciones químicas generalmente chicos las vitaminas que son co enzimas son las vitaminas del complejo b profe entonces entonces chicos y que te quede para siempre una enzima
activa una o lo encima esa que james es aquella up o enzima que se ha unido con quien como un factor bien por acá chico sigamos y vamos a ver cómo es que actúa una enzima entonces vamos a ver ahora la acción enzimática vamos a ir por partes ve por aquí en primer lugar chicos tengo una enzima encima hace algo chicos en primer lugar viene el reconocimiento del sustrato mira ve reconocimiento del sustrato en segundo lugar chicos tienen la fijación del sustrato la fijación del sustrato es cuando la enzima se une con el sustrato la
enzima se acopla al sustrato y entonces chicos a la unión enzima sustrato se le conoce con el nombre de complejo de michelis entonces este complejo que está aquí chicos de nuevo se llama complejo demichelis o complejo enzima sustrato ese complejo puede ser de dos tipos no entonces el primero chicos hablamos del modelo de richard el modelo de richter también se llama si no se llama llave cerradura es cuando escúchame bien cuando la forma del sitio activo coincide con la forma de quien del sustrato entonces chicos es como si yo tuviera una llave y una cerradura
encajan a la perfección ahora mira el siguiente modelo es el modelo de coche la el modelo de coach line quiero que veas primero acá la encima y acá el sustrato que pasa aquí [Música] como te darás cuenta escúchame bien la forma del sitio activo no coincide con la forma del sustrato entonces seguramente pensarás profe y entonces no se forma el complejo pues pasa esto no que la enzima chicos la enzima se adapta a la forma de quien del sustrato y de todas maneras se produce este complejo enzima sustrato entonces acá chicos modelo de fichero y
por aquí teníamos el modelo de quien de coslada me por aquí una vez chicos que se ha formado este complejo tiene la acción catalítica los aminoácidos catalíticos del sitio activo van a transformar chicos este sustrato en que en productos y una vez que se obtienen los productos viene la última etapa no los productos chicos se liberan del ciclo activo y la enzima escúchame bien la enzima queda libre para nuevamente realizar otra reacción química quiero que sepas algo mira las enzimas no se consumen en la reacción por eso vamos a decir que las enzimas son que
reutilizables las enzimas chicos no forman parte de los productos quien se convierte en productos una una cosita a quienes es el sustrato ahora déjame decirte algo hay factores chicos que afectan la velocidad de la reacción enzimática en primer lugar la temperatura escúchame cuando la temperatura aumenta mira ve cuando la temperatura aumenta la velocidad de la reacción también aumenta y decir chicos que se hace más rápida en otras palabras chicos no a mayor temperatura la velocidad de la reacción aumenta ok pero no te olvides que si aumentamos mucho la temperatura la enzima es inactiva y obviamente
ya no tiene actividad profe y segundo lugar la concentración de la enzima si nosotros aumentamos mira por aquí la concentración de la enzima entonces también aumenta la velocidad de la reacción química entonces si aumentamos la concentración de la enzima la reacción va más rápido y qué pasa si aumentamos la concentración del sustrato si aumentamos la concentración del sustrato también la velocidad de la reacción aumenta pero hasta cierto punto no hasta que chicos el sustrato satura el sitio activo y entonces ya no puede aumentar la velocidad de la reacción se queda estable en un determinado en
una determinada concentración del sustrato ok bien chicos estos fueron los factores que afectan la velocidad de la reacción enzimática para terminar aquí alguito más no aquí chicos tenemos una amiguita no una pregunta cómo se llama pre enzima la pre enzima va a ser va a ser chicos afectada por un inductor el inductor chicos actúa sobre esta pre enzima y sabes que le quita una parte y cuando está por encima le quitas una parte se convierte en que en una enzima obviamente ya con actividad catalítica probablemente no me entiendas así que voy como un ejemplo chicos
en el estómago tenemos una pre enzima esa pre enzima se llama así no pregunta cómo se llama pep sino gen o déjame decirte que el pepsi no gen o es producido por unas células las células y mojen as o peptídicas s p's y no je no es una enzima inactiva no funciona sin embargo chicos en el estómago hay un inductor es inductor es el ácido clorhídrico y cuando el ácido clorhídrico actúa sobre el pepsi no je no pues que le quita una parte y cuando a éste pep sino que no le quita una parte se
convierte en una enzima y esta enzima adivina adivina se llama así no pregunta cómo se llama que las enzimas chicos se van a clasificar no de acuerdo no a un comité internacional de encima kiko y porque se clasifican chicos en 6 grupos y adelante que son 6 grupos se van a clasificar de acuerdo a la reacción química que cataliza ok entonces tenemos las primeras la primera chico son las óxidos reductasa [Música] el anuncio de resultados chicos catalizan la oxidación de un sustrato con la reducción simultánea de otros sustratos o coenzima es decir chicos que mientras
alguien se oxida el otro se reduce entendido vamos a verlo aquí observar si tú tienes aquí una molécula chicos que está reducida o sea tiene hidrógenos y la vamos a unir con otro sustrato entonces ocurre chicos que el primer sustrato pierde hidrógeno se oxida y el otro gana hidrógenos se reduce entendido como veis acá se oxida 1 y se reduce el otro esas son las reacciones químicas de óxido de reducción y quien las cataliza estas enzimas no las enzimas oxido reductasa por ejemplo acá tienes el alcohol si nosotros chicos le agregamos nada entonces chicos el
alcohol inmediatamente qué pasa pues chicos que se oxidan y se convierte en que aldehído y simultáneamente en nada se reduce y esa reacción química es está canalizada por una enzima la enzima alcohol deshidrogenasa tú sabes tú sabes que el alcohol chicos llegar a ser tóxico y el alcohol tiene que degradarse entendido y para eso existe esa enzima es enzima chicos la cantidad en el organismo depende de qué depende del sexo en los varones hay más de esta enzima y por esa razón generalmente los valones toleran mayor nivel de alcohol que las mujeres porque tienen en
mayor cantidad esta enzima sigamos avanzando un ratito más dentro de las oxido reductasa sólo puse por acá para no interferir mirando dentro de la sociedad o reeducadas tenemos otras que adicionan oxígeno en ese grupo por si acaso están las peroxidasa las catalanas las oxigena sas y las oxidadas te vuelvo a repetir que estas óxidos reductasa no adicionan qué cosa oxígeno estamos regresemos chicos por acá vamos a hablar del segundo grupo de enzimas el segundo grupo de enzimas son las transferencias [Música] chicos número 2 las transferencias como su nombre indica las transferencias y cost transfieren un
grupo diferente al oxígeno de un sustrato a otro sustrato profe y cómo es esto escúchame por ejemplo por ejemplo acá tengo un sustrato profe y tiene un grupo sí o no si saben que en la reacción ese grupo aparece en el otro profe y me explica mejor mediante un ejemplo pues claro mira ve acá tienes y la atp tú sabes que el atp es de fosfato profe y cuando reacciona con la glucosa escúchame s atp pierde un fosfato que lo gana a quien la glucosa y él se queda como que adenosín trifosfato a dp profe
y la glucosa se fosforila y entonces tenemos ahora a la glucosa 6 fosfato profe que esta reacción la conozco claro esa reacción la conoces en la primera reacción de que de la glucólisis y es canalizada por una enzima no pregunta cómo se llama la enzima ex osa quinasa y de nuevo no aquí chicos el grupo de un sustrato mira mira se va a pasar al otro sustrato mira ve el grupo que estaba aquí ahora está acá y entonces chicos tenemos la formación de quien de glucosa 6 fosfato estamos de acuerdo seguimos por acá vamos ahora
con las hidrolasas [Música] como su nombre lo indica van a añadir agua para romper qué cosas para romper enlaces entonces hidroliza en este des éteres hidrolizada en gracia peptídicos enlace glucose hídrico y como ya te dije añaden agua para romper el inglés dentro de ese grupo están chicos todas las enzimas digestivas está bien por ejemplo no situ acá tienes un sustrato y le añades agua entonces obtienes dos nuevos productos bs dos nuevos sustratos profe y cómo es esto escúchame por ejemplo si tienes sacarosa y tú le añades agua entonces chicos esta reacción canalizada por encima
por encima por encima aquí mira el enzima sacar afa no te olvides que las enzimas se le denomina cambiando la ossa entonces chicos al actual esta enzima obtenemos una pregunta que obtenemos o fructosa y glucosa esos chicos son más enzimas que cosas y drogas y como te vuelvo a repetir rompen enlaces adicionando agua siguiente chicos las diosas [Música] a la alianza chico remueve en grupo de sustrato o rompe enlaces por mecanismos diferentes a la hidrólisis o sean diferente a eso profe no entiendo mira ven por ejemplo si tú acá tienes una molécula a y actual
encima entonces tienes dos nuevos dos nuevos compuestos pero profe la diferencia es que acá no se usaba la diferencia con esto te diste cuenta que creo que si ahora mira si tienes a la fructosa 16 y fosfato o de fosfato y actual enzima la enzima aldo la sap es la cuarta reacción de la glucólisis te acuerdas pues creo que sí y sabes que ahí tenemos dos compuestos line de hidroxi acetona y el glitter aldehído 3 fosfato esos amiguitos de acá resultaron chicos de la ruptura de esta molécula que saca por acción de la enzima no
una pregunta cómo se llama la enzima aldo la sal siguiente chicos ahora vamos a hablar de las enzimas y someras as o no las isomerasa producen isómeros ópticos geométricos o posicionales de un sustrato profe o sea sea hijo que un sustrato se pasa a un sustrato ve pero siempre y cuando ambos sean que cosas y sombreros a prophet no entiendo mucho por ejemplo mira y como la segunda reacción de la glucólisis tú sabes que la glucosa fosforilada se convierte en que en fructosa 6 fosfato tanto la glucosa como la fructosa una pregunta qué cosas son
isómeros y entonces ahí actúa una enzima que se llama ex osa isomerasa y la ex o si se mira a chicos convierte a la glucosa en su y somero que se llama como frutos ser ok tranquilo que soy fácil ya hablamos chicos de que enzimas ligadas [Música] o no como su nombre indica no ligar liga estos chicos unen dos sustratos con la hidrólisis de atp escúchame acá hay dos las in de tasas esas amiguitas chicos son enzimas que depende de la atp y participan en bio síntesis y las otras zonas de sintas as que también
catalicen reacciones de síntesis pero que no requieren atp directamente entonces por ejemplo mira ve si acá te tienes un sustrato y le vas a añadir dióxido de carbono y hay presencia de atp entonces una preguntita de quién estamos hablando de una enzima no cómo se llama sintetasa profe a ver a ver y se obtiene un producto chicos que tiene que tiene qué cosas chicos el carbono y además chicos una pregunta tiene esa de p y fosfato inorgánico profe no entiendo eso tranquilo si acá tienes acetil coenzima y de adiciones dióxido de carbono pero utilizando atp
entonces chicos acá se obtiene el malón y coenzima masa de mafoff aquí no orgánico profe en catalán esta reacción pues esta reacción chicos una pregunta a quien la cataliza la enzima acetil coenzima carboxilasa o no no [Música]





![[BIOLOGÍA] ENZIMAS | VITAMINAS | ESTRUCTURA | CLASIFICACIÓN | FUNCIONES | CICLO ANUAL](https://img.youtube.com/vi/wVLhOGJPU1k/mqdefault.jpg)

![[ BIOLOGÍA FREE ] - ENZIMAS | Metabolismo Celular 👉😍🌿](https://img.youtube.com/vi/7SF3GytcFyg/mqdefault.jpg)

